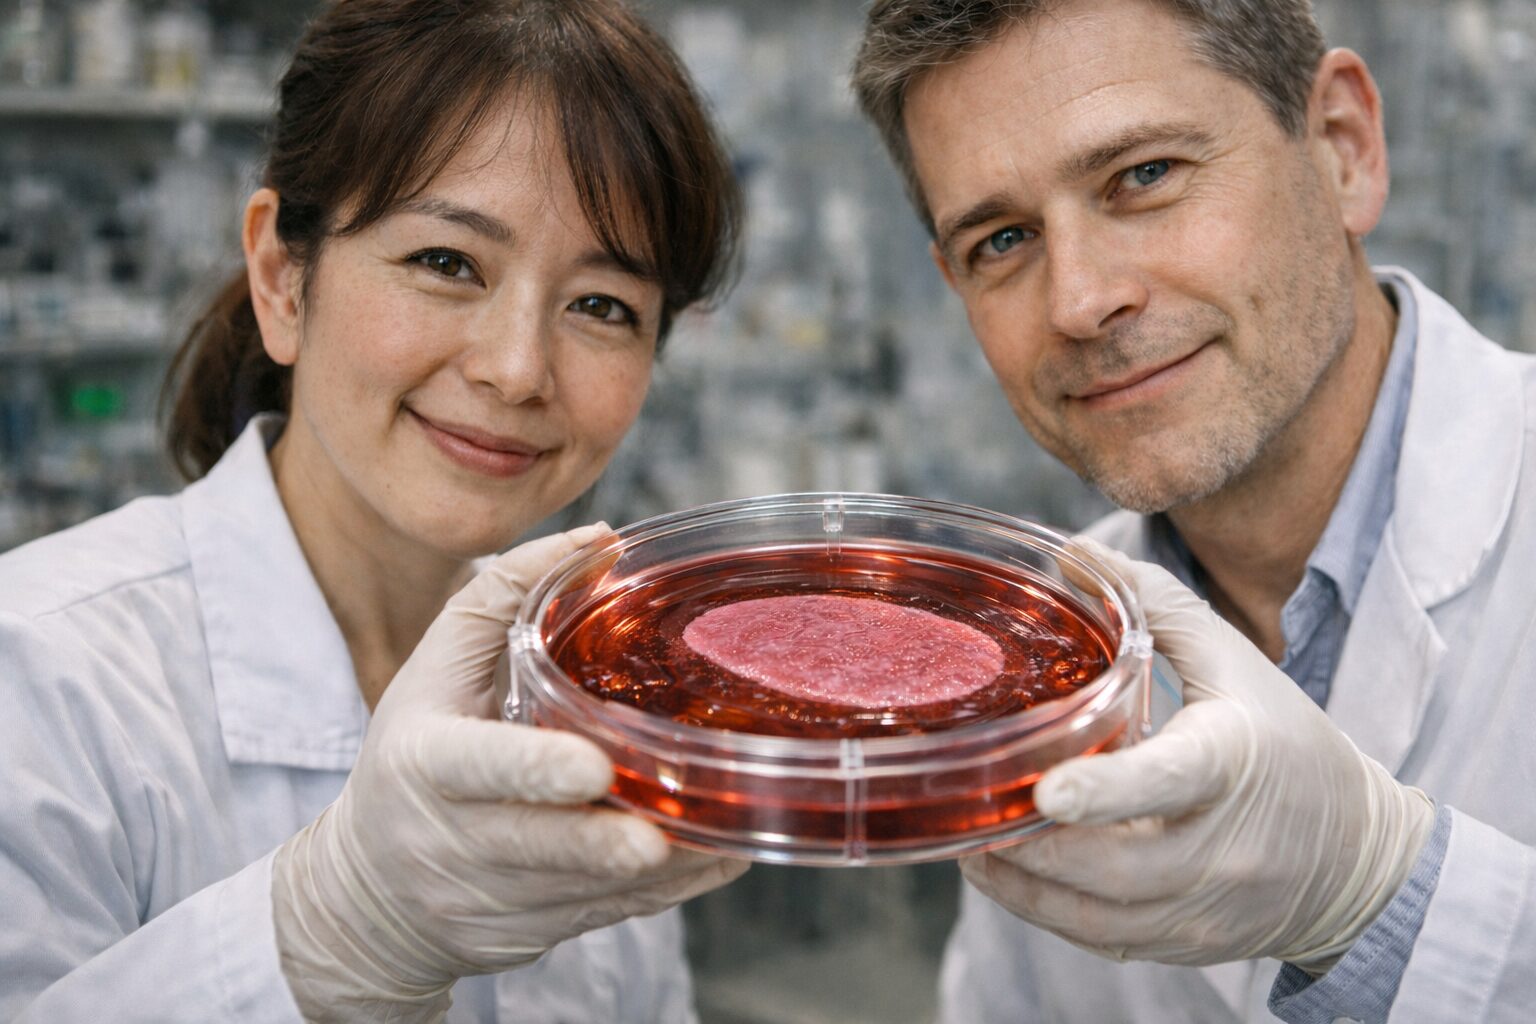

iPS細胞の日は、体細胞から多能性を持つ細胞を生成し、失われた機能や組織を再構築する技術の進展と、その社会的意義を考える記念日です。
iPS細胞(人工多能性幹細胞)は、皮膚や血液などの体細胞に特定の因子を導入することで、さまざまな細胞へと分化可能な状態へ初期化する技術であり、**生命の状態そのものを可逆的に制御する“生命再設計技術”**として位置づけられます。
従来の医療が「損傷した機能を補う」ものであったのに対し、iPS細胞は失われた組織や臓器そのものを再構築する“構造回復型医療”**を可能にします。これにより、神経疾患、心疾患、視覚障害など、これまで治療が困難とされてきた領域において、新たな治療の道が開かれています。
さらに、患者自身の細胞をもとに作製することで拒絶反応のリスクを低減できるほか、疾患モデルの作製や創薬への応用により、医療開発プロセスそのものを変革する基盤技術としての役割も担っています。
また、iPS細胞は単なる再生医療にとどまらず、ゲノム編集やバイオテクノロジーと融合することで、生命の設計・制御・最適化を行う次世代の生命科学基盤へと進化しています。
一方で、倫理・安全性・長期的影響に関する課題もあり、社会的合意と制度設計の重要性も高まっています。
このようにiPS細胞は、
生命を“修復する対象”から“設計可能な存在”へと転換する中核技術です。
iPS細胞の日は、こうした技術の進展と社会的意義を共有し、医療と生命科学の未来、そして人間のあり方そのものを考える契機となる記念日として位置づけられます。
※ 本サイトの一部画像は、AI生成によるイメージを内容理解の補助として使用していますが、実在の人物・団体・場所とは関係ありません。